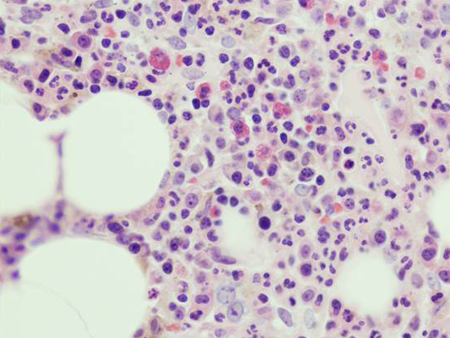

Images and videos
Images

Monoclonal gammopathy of undetermined significance
CD138 immuno-histochemical staining highlighting small clusters of plasma cells
From the collection of Ola Landgren, MD, PhD
See this image in context in the following section/s:

Monoclonal gammopathy of undetermined significance
Using electrophoresis and immunofixation, figure A shows normal results while figure B shows evidence of an IgA kappa MGUS with polyclonal IgG background
From the collection of Ola Landgren, MD, PhD, courtesy of Dr Jerry Katzmann, Mayo Clinic, Rochester, MN
See this image in context in the following section/s:
Monoclonal gammopathy of undetermined significance
Haematoxylin-eosin section of bone marrow biopsy showing mild increase in plasma cells
From the collection of Ola Landgren, MD, PhD
See this image in context in the following section/s:
Use of this content is subject to our disclaimer


